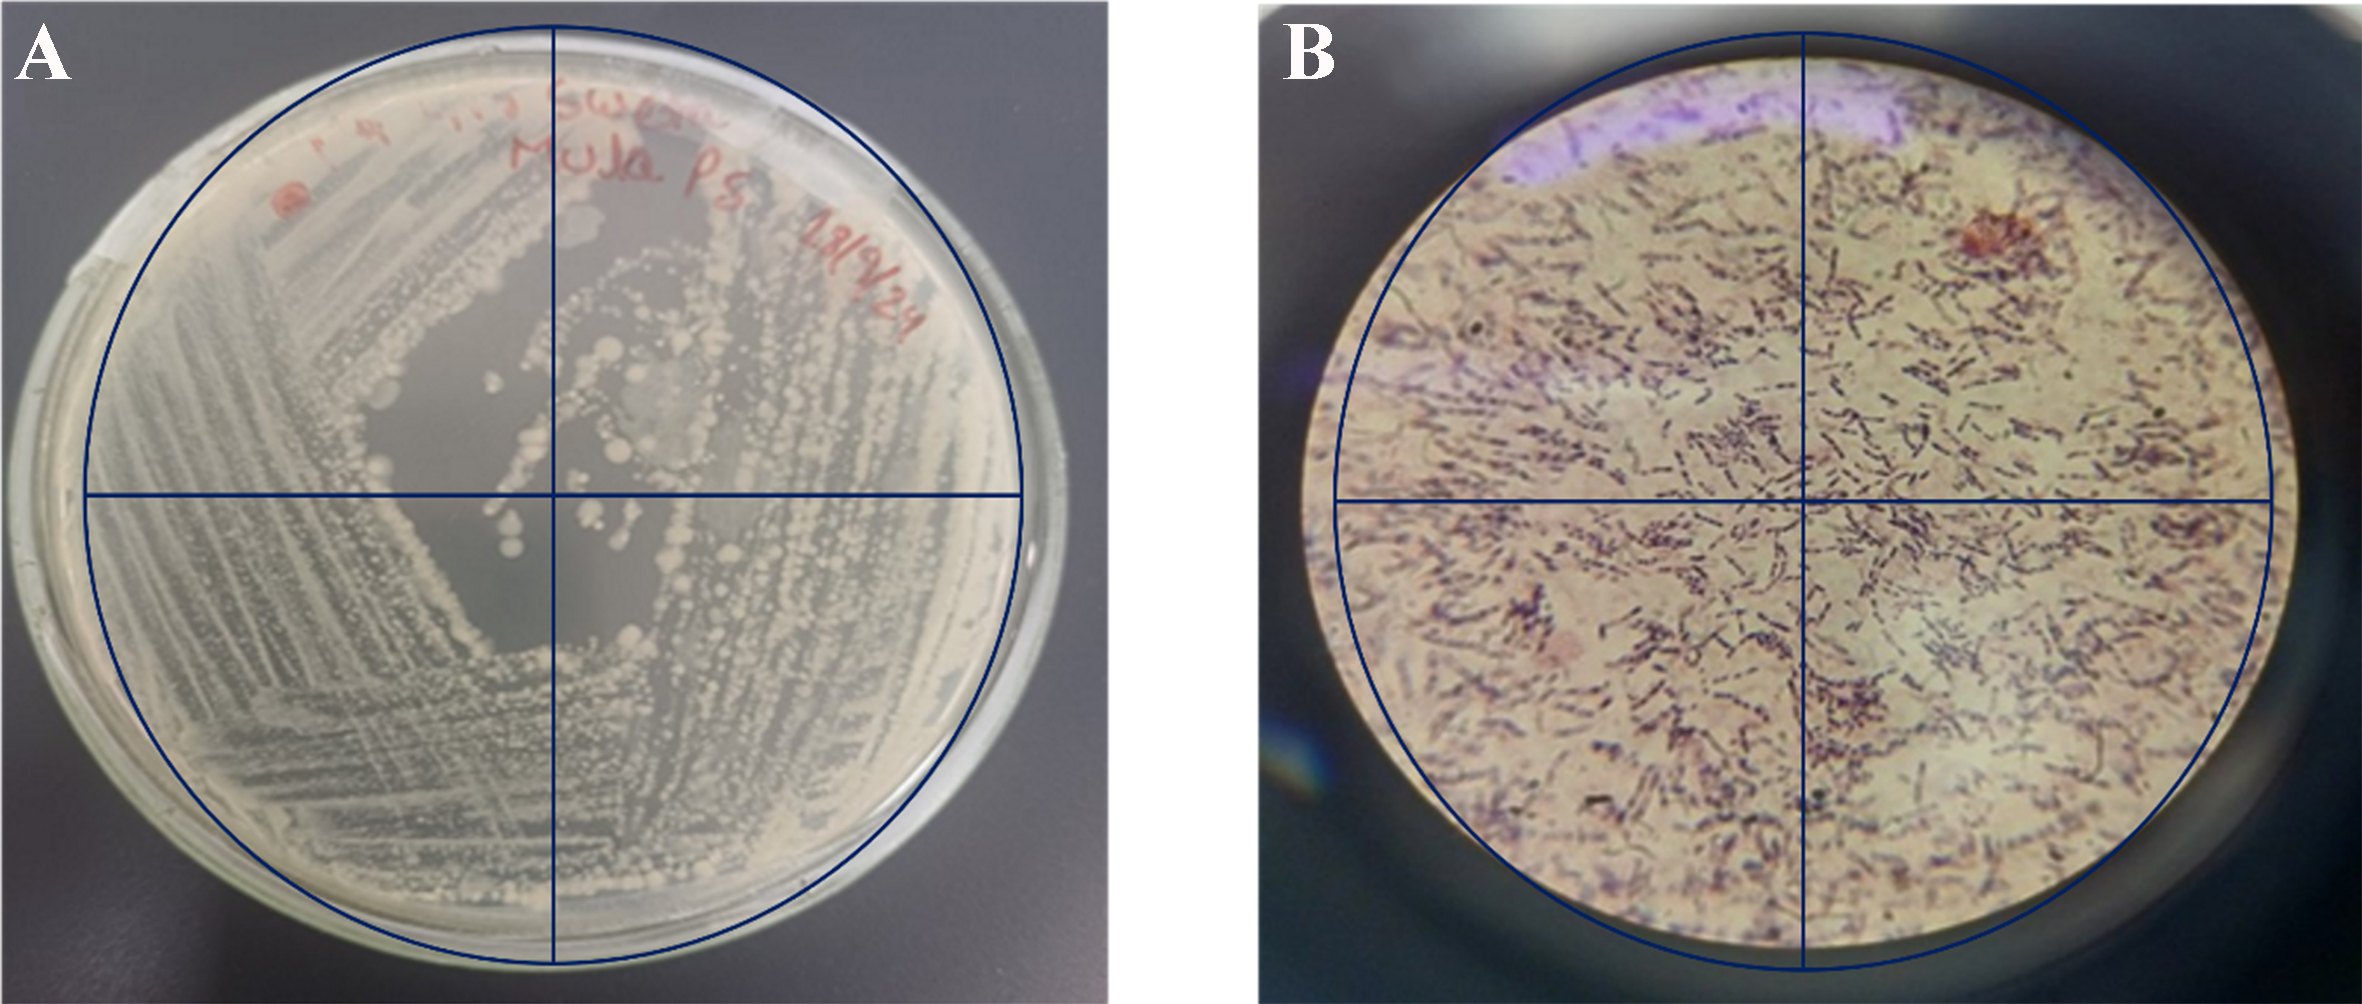

Microbial biodegradation of polystyrene microplastics: isolation, characterization and degradation efficiency of a river-isolated bacterium
Abstract
Microplastic (MP) pollution, especially from polystyrene (PS), presents a serious threat to aquatic ecosystems due to its persistence and resistance to biodegradation. In the present study, a bacterium identified as Bacillus cereus was isolated from the polluted Mula River in Pune, and its potential to degrade PS MPs was evaluated under controlled laboratory conditions. Morphological analysis confirmed it as a Gram-positive, rod-shaped, motile organism. The strain exhibited distinctive colony characteristics, including rough texture, opaque appearance and irregular margins. Biochemical profiling revealed positive results for methyl red, Voges-Proskauer, citrate utilization, and catalase tests, indicating metabolic versatility and oxidative tolerance. Molecular identification was conducted using 16S rRNA gene sequencing. The amplified 16S rRNA sequence (~1,392 bp) was analyzed using BLASTN against the NCBI database, showing 100% sequence similarity with known Bacillus cereus strains (e.g., Bacillus cereus strain BM1, KU871054.1; Bacillus cereus strain 4-813, MW052587.1), thereby confirming its taxonomic identity. Phylogenetic analysis using MEGA software further supported its placement within the Bacillus cereus clade. Bacillus cereus grew effectively in minimal salt medium (MSM) with PS as the sole carbon source, achieving an optical density (OD) of 0.80 at 600 nm over 30 days. Biodegradation efficiency, assessed by dry weight loss of PS, showed a 20% reduction. The calculated degradation rate constant was 0.00758 g/day, corresponding to a half-life of 91.48 days. Fourier transform infrared (FTIR) spectroscopy revealed notable chemical modifications, including the appearance of hydroxyl and carbonyl functional groups and diminished aromatic C–H stretching, suggesting oxidative cleavage of the polymer backbone. Scanning electron microscopy (SEM) provided visual evidence of biofilm-mediated degradation, revealing dense extracellular polymeric substance (EPS) layers, bacterial embedment, and pronounced surface erosion. Even after biofilm removal, the PS surface retained pits and fissures, indicating irreversible microbial degradation. This integrated analysis highlights the potential of indigenous Bacillus cereus for the bioremediation of PS MPs through biofilm formation and enzymatic activity. The findings contribute to the growing field of MP biodegradation and support further exploration of microbial approaches for sustainable plastic waste management.
Keywords
INTRODUCTION
Microplastics (MPs), owing to their minute size and large surface area, create an ideal niche for microbial colonization and biofilm formation in aquatic environments. Among these, polystyrene (PS) - a synthetic, aromatic and non-biodegradable polymer - is one of the most widely used and frequently detected plastics in both freshwater and marine ecosystems[1,2]. Global plastic production continues to rise, reaching approximately 400 million tonnes in 2022, which underscores the persistent challenge of managing plastic waste despite growing awareness and mitigation efforts[3]. Rivers serve as major conduits, transporting 70%-80% of plastic debris from terrestrial sources into the oceans, a process influenced by factors such as population density, urban runoff, and inadequate waste management in river basins[4,5]. Once introduced into aquatic systems, MPs undergo fragmentation, photo-oxidation, and surface modification while adsorbing pollutants, nutrients, microbial cells, and dissolved organic matter.
PS is extensively utilized in packaging, disposable cutlery, insulation, and various consumer products due to its durability, light weight, and thermal insulation properties[6-8]. However, these very features also contribute to its persistence in natural environments. Unlike biodegradable materials, PS resists physical, chemical, and biological degradation, resulting in its accumulation in terrestrial and aquatic ecosystems[9]. Its chemical structure, characterized by aromatic rings and high hydrophobicity, confers exceptional stability and limits microbial enzymatic access[10,11]. Aromatic polymers such as PS are particularly resistant to degradation because of their structural rigidity and low surface area available for enzymatic attack.
Despite these challenges, several microorganisms, particularly bacteria and fungi, have shown the potential to degrade PS through mechanisms involving surface colonization, biofilm formation, enzymatic oxidation, and metabolic processing[12,13]. Microbial degradation typically begins with colonization of the polymer surface, followed by biofilm establishment, secretion of extracellular enzymes, hydrolytic cleavage of polymer chains, and eventual mineralization into simpler molecules such as CO2 and H2O[14,15]. Biofilm formation is particularly important as it provides a structured microenvironment that supports microbial adhesion, enzyme production, and improved substrate accessibility[16].
Specific bacterial taxa, including Rhodococcus ruber, Pseudomonas putida, Exiguobacterium sp., Bacillus cereus, and Streptomyces spp., have been shown to attach to PS surfaces, form dense biofilms, and initiate polymer breakdown[1,2]. These oxidative modifications weaken the polymer, promoting fragmentation and, under aerobic conditions, eventual mineralization. Scanning electron microscopy (SEM) studies have revealed surface pitting, cracking, and reduced hydrophobicity of PS after microbial treatment[17]. Furthermore, bacteria such as Pseudomonas putida and Bacillus cereus isolated from polluted river ecosystems have shown the capability to degrade PS MPs by forming robust biofilms under both normal and heavy metal-stressed conditions. Table 1 shows several PS-degrading bacterial strains along with their sources and experimental results[18].
PS-degrading bacterial strains
| Strain | Source | Substrate and incubation time | Experiment results | Ref. |
| Pseudomonas putida | Soil and compost | PS foam, 30 days | Biofilm formation; FTIR showed C=O peak; surface erosion observed | [18] |
| Exiguobacterium sp. | Landfill soil | PS film, 20 days | Surface cracks; increased hydrophilicity | [19] |
| Rhodococcus ruber | Marine plastic surface | PS film, 8 weeks | Gradual roughening; biofilm persistence confirmed by SEM | [20] |
| Acinetobacter johnsonii | Industrial wastewater | PS beads, 14 days | FTIR showed new peaks; SEM revealed surface etching | [21] |
| Klebsiella pneumoniae | Urban solid waste | PS powder, 21 days with glucose | Enhanced degradation in the presence of co-substrate | [22] |
| Streptomyces sp. | Forest topsoil | PS film, 15 days | Polymer softening; enzyme activity detected | [23] |
| Arthrobacter sp. | Compost heap | PS fragments, 28 days | Biofilm formation and surface pitting observed | [24] |
PS MPs are also associated with the adsorption and transport of polyaromatic hydrocarbons in aquatic environments, posing significant ecological and human health risks. Given these challenges, the present study investigates a novel bioremediation approach by isolating and characterizing a bacterial strain from a PS MP-impacted river ecosystem, with the aim of enhancing degradation potential and mitigating environmental risks. In addition to experimental analyses, we performed a keyword network analysis using VOSviewer with the terms “bioremediation”, microplastic degradation”, “polystyrenes”, and “bacterium”. The analysis identified “bioremediation”, “bacterium”, “microbial diversity”, and “enzyme activity” as some of the most strongly connected research themes [Figure 1], underscoring the relevance and urgency of seeking microbial degradation pathways across diverse contaminants. Our study integrates in-depth physiological, biochemical, and degradation efficiency analysis and provides one of the first transcriptomic insights into the PS-degrading potential of riverine microbial communities. Importantly, this research advances the frontier of MP bioremediation and opens new opportunities to harness naturally occurring microbial resources as a basis for sustainable technologies to combat plastic pollution.
Figure 1. Bioremediation research: a visual mapping of thematic clusters related to MP pollution. MP: Microplastic.
This study focuses on the isolation and characterization of bacteria capable of degrading PS MPs from the Mula River, Pune. By assessing microbial growth, biofilm formation, degradation efficiency, and structural modifications using Fourier transform infrared (FTIR) spectroscopy, we aim to provide insights into the biodegradation potential of isolated bacterial strains. Degradation kinetics will be evaluated by calculating reduction rate constants and estimating half-lives, offering valuable information for developing effective bioremediation strategies. The findings of this study contribute to the growing body of knowledge on microbial plastic degradation and offer potential solutions for mitigating the environmental impact of plastic pollution.
EXPERIMENTAL
Sample collection and bacterial isolation
Biofilm-containing samples were collected from PS surfaces immersed in water from the polluted Mula River. The PS samples were left submerged in the polluted river water for seven days to allow microbial colonization and biofilm formation. After incubation, biofilms were scraped from the PS surfaces using a sterile Nichrome wire loop under aseptic conditions.
The collected biofilms were inoculated into sterile nutrient broth (NB) and incubated at 37 °C for 48 h under shaking conditions (120 rpm) to promote microbial growth. The obtained suspension was serially diluted and spread on nutrient agar (NA) plates, which were incubated at 37 °C for 24 h following the established procedure[25]. All experiments were performed in triplicate to ensure accuracy and reproducibility.
Following initial growth, distinct bacterial colonies were further isolated using the four-quadrant streaking method to obtain pure cultures. This technique ensured the separation of individual colonies, which were characterized based on colony morphology (shape, size, margin, elevation and pigmentation) and subjected to a series of biochemical tests for preliminary identification. Colonies with varying morphological characteristics were selected, purified, and maintained on NA slants and plates for further analysis. A single colony was subsequently picked from a NA plate and purified through repeated subculturing to obtain a pure culture. Genomic DNA was extracted from the purified culture and used as a template for amplification of the 16S rRNA gene with universal bacterial primers 27F and 1492R. Each 20 μL PCR reaction contained 100 ng of DNA, 10X buffer, 0.1 mM dNTPs, 0.5 μM of each primer, and 2 U of Taq polymerase (TaKaRa TaqTM R001C). PCR conditions were as follows: initial denaturation at 95 °C for 3 min; 32 cycles of denaturation at 95 °C for 30 s, annealing at 42 °C for 30 s, and extension at 72 °C for 1 min; followed by a final extension at 72 °C for 10 min. Amplification yielded products of ~1,200 bp, which were confirmed by electrophoresis on a 1.5% agarose gel stained with ethidium bromide and visualized under UV light.
Sequencing was performed using the Sanger method on a 3500 XL-ABI genetic analyzer. The 16S rRNA gene of the bacterial isolate was successfully amplified and sequenced. Forward and reverse reads were assembled into a single contig (CONTIG_B6) of approximately 1,392 base pairs. The consensus sequence was analyzed using BLASTN against the NCBI nucleotide database for species-level identification.
Biodegradation experiment
The biodegradation potential of the isolated bacterial strains was evaluated using mineral salt medium (MSM) containing PS MPs as the sole carbon source. PS MPs were prepared by cutting PS sheets into small square pieces (approximately 1 × 1 cm), sterilizing them by immersion in 70% ethanol overnight, and drying at 50 °C for 24 h. The biodegradation assay was performed under sterile conditions over a 30-day incubation period. The composition of MSM (per litre) included: NaCl (0.5 g), K2HPO4 (1.0 g), KH2PO4
Sterilized PS MPs were added to the MSM, and each flask was inoculated with 10% (v/v) of the bacterial inoculum. The flasks were incubated at ambient room temperature (26-28 °C, average 26.8 °C) with continuous shaking at 120 rpm. The temperature remained stable throughout the experiment. Bacterial growth was monitored at regular intervals by measuring the optical density (OD) at 600 nm using a spectrophotometer. The initial pH of the MSM was adjusted to 7.0 using 1N NaOH or 1N HCl, verified with a calibrated digital pH meter. After incubation, the final pH was recorded as 7.16. The optimal conditions during the experiment were a pH of 7.16 and a temperature of 26.8 °C. Biodegradation efficiency was quantified by measuring the percentage weight loss of PS MPs before and after incubation. Plastic pieces were washed thoroughly with 2% (v/v) aqueous sodium dodecyl sulphate to remove attached biofilms, rinsed with sterile distilled water, and dried at 50 °C for three days before weighing.
Determination of Dry Weight: Polymer degradation was expressed as percentage weight loss (%)
Determination of Reduction Rate: The rate constant of MP polymer reduction was determined using a first-order kinetic model
where K is the first-order rate constant for polymer degradation (day-1), t is the incubation time (days), W is the residual polymer weight, and Wo is the initial polymer weight (g).
Determination of Half-life of residual MPs: The half-life (t1/2) was calculated as
All experiments were conducted in triplicate to ensure reproducibility. Controls included MSM containing PS MPs without bacterial inoculation to account for potential abiotic degradation.
Biofilm formation assay
Biofilm formation on PS MPs was assessed using polluted water from the Mula River, Pune, as the microbial source. Sterile PS pieces were immersed in the river water and incubated under static conditions at 28 ± 2 °C for 7 days. Visible biofilm developed on the PS surfaces, which was gently scraped under sterile conditions and inoculated into 10 mL of NB. The culture was then incubated at 37 °C for 48 h to enrich biofilm-associated bacterial communities.
Quantitative assessment of biofilm on PS MPs was performed using the crystal violet (CV) staining method[26,27]. Four PS pieces were placed in sterile Petri dishes, rinsed three times with sterile water and air-dried for 45 min. The samples were stained with 0.5 mL of 1% CV for 45 min at room temperature, washed thrice with sterile water and dried for another 45 min. The stained PS pieces were transferred to 2 mL centrifuge tubes, decolorized with 1 mL of 95% ethanol for 10 min, and the absorbance of the resulting solution was measured at 595 nm. Treatment with ethanol alone served as the blank control, while commercial virgin PS served as the experimental control. All experiments were conducted in triplicate.
FTIR analysis
FTIR spectroscopy was employed to evaluate structural and chemical changes in PS MPs before and after microbial degradation. The samples were prepared by washing the PS pieces with distilled water and drying them at 50 °C for 24 h. FTIR analysis was performed using an FTIR spectrometer in the range of 4,000-
SEM analysis
Changes in the surface morphology of PS MPs after 30 days of incubation with isolated bacteria were analyzed using a SEM Quanta 200 3D (Thermo-Fisher Scientific). Both degraded and control MPs were sputter-coated with a gold layer and subsequently examined under SEM[28]. To assess biofilm formation, sterile PS film pieces were added to MSM inoculated with the bacterial culture and incubated at 28 ± 2 °C on a rotary shaker at 120 rpm for 30 days. A control setup containing uninoculated MSM and PS was maintained in parallel. At the end of incubation, PS films were removed from the medium and air-dried. SEM observations revealed extensive bacterial colonization and dense extracellular polymeric substance (EPS) layers on the PS surface, confirming biofilm formation. The presence of biofilms indicated bacterial adhesion and their potential role in the initial stages of PS degradation.
RESULTS AND DISCUSSION
Bacterial growth and degradation efficiency
The bacterium isolated from the Mula River demonstrated substantial growth when cultured in MSM supplemented with PS MPs as the sole carbon source. During the 30-day incubation period, the culture achieved a maximum OD of 0.80, indicating robust growth in the PS-containing medium. This result suggests that the bacterium was able to utilize PS as a carbon source to sustain its growth.
The isolate was first cultured in NB at 37 °C to promote active cell proliferation. For the PS degradation experiment, flasks were incubated at room temperature (approximately 26-28 °C) on a rotary shaker at
Morphological, cultural and biochemical characteristics of the bacterial isolate
Figure 2 illustrates the colony morphology and cellular structure of the bacterium isolated from PS MPs in polluted river water. Figure 2A colonies grown on NA after 24-48 h of incubation at 37 °C appear large, flat, irregularly spreading, and dull grey, with a frosted-glass appearance. This distinctive colony morphology, along with a sour or fruity odor, supports the preliminary identification of Bacillus cereus. Figure 2B shows a Gram-stained image of the isolate under 100× oil immersion, revealing Gram-positive rod-shaped cells that occur singly, in pairs, or in short chains - characteristics consistent with Bacillus cereus. The cells measured approximately 3-5 µm in length and 1.0-1.2 µm in width. When these observations were combined with the results of biochemical tests (methyl red, Voges-Proskauer, citrate utilization, and catalase), the isolate was confirmed as a strain of Bacillus cereus. These morphological and biochemical features are summarized in Table 2.
Figure 2. (A) Four-quadrant streaking of the bacterial isolate obtained from PS-enriched medium showing distinct colony morphology on NA; (B) Gram staining of the same isolate observed under a microscope, revealing Gram-positive rods. PS: Polystyrene; NA: nutrient agar.
Morphological, cultural and biochemical characteristics of the bacterial isolate
| Category | Characteristic | Description |
| Morphological | Shape | Rod-shaped |
| Size | 3-5 µm long, 1.0-1.2 µm wide | |
| Arrangement | Single, pairs, or short chains | |
| Gram reaction | Gram-positive (can be Gram-variable) | |
| Motility | Motile (peritrichous flagella) | |
| Capsule | Usually non-capsulated | |
| Cultural | Colony morphology (NA) | Large, flat, irregular, rough, dull grey, frosted-glass appearance |
| Odor | Fruity or sour milk-like | |
| Pigmentation | Non-pigmented | |
| Catalase | Positive | |
| Oxidase | Negative | |
| Biochemical | Indole | Negative |
| Methyl red | Positive | |
| Voges-Proskauer | Positive | |
| Citrate utilization | Positive |
Molecular identification and phylogenetic analysis of bacterial isolate (B6)
The sequencing data obtained from both forward and reverse primers were assembled into a single consensus contig (CONTIG_B6) of approximately 1,392 base pairs. The sequence was analyzed using BLASTN against the NCBI nucleotide database, which showed 100% query coverage and 100% identity with multiple Bacillus cereus strains, including strain BM1 (Accession: KU871054.1), strain KTO20-1A (MT909747.1), and others. These results strongly confirm that isolate B6 belongs to the species Bacillus cereus, a Gram-positive, spore-forming bacterium commonly found in soil, water, and food environments [Figure 3].
Figure 3. BLASTN analysis of the 16S rRNA sequence of sample B6 showing 100% identity and coverage with multiple Bacillus cereus strains.
To further confirm the identification and examine evolutionary relationships, a phylogenetic tree was constructed using the Maximum Likelihood method based on the Tamura-Nei model in MEGA11 software. The analysis included a total of 11 sequences, and the tree with the highest log likelihood value (-3,781.68) was selected. Initial topologies were inferred using the Neighbor-Joining and BioNJ methods, and the final topology was refined for optimal likelihood. A total of 1,466 aligned nucleotide positions were included in the dataset. The phylogenetic tree [Figure 4] placed isolate B6 within a strongly supported clade of well-characterized Bacillus cereus strains, thereby validating the BLAST-based taxonomic assignment.
Figure 4. Phylogenetic tree of sample B6 based on 16S rRNA gene sequences, showing close clustering with Bacillus cereus strains.
The combination of complete sequence identity and consistent clustering in the phylogenetic analysis demonstrates the reliability of 16S rRNA sequencing for accurate bacterial identification. Confirmation of isolate B6 as Bacillus cereus provides valuable insight into its ecological role and potential applications, especially in environmental and biodegradation studies, where members of this species are known for their diverse metabolic capabilities.
Figure 4 illustrates the top BLAST hits of CONTIG_B6 aligned with closely related Bacillus cereus strains, along with the constructed phylogenetic tree depicting the evolutionary relationship of the isolate. The nucleotide sequence of the 16S rRNA gene of Bacillus cereus strain PS-Mula has been deposited in the NCBI GenBank database under accession number PV999201.
To assess the biodegradation efficiency of Bacillus cereus on PS MPs, triplicate experiments were conducted under controlled conditions over 30 days. The initial weight of PS was maintained at 0.030 g across replicates. Final weights ranged from 0.0235 to 0.0242 g, corresponding to weight loss percentages of 19.33% to 21.67%, with a mean reduction of 20.33% ± 1.20%. These results indicate a consistent degradation pattern, demonstrating the bacterium’s active role in polymer breakdown.
An independent two-tailed t-test was conducted to compare the mean weight loss of PS MPs between the Bacillus cereus treatment and control groups (MSM + PS without bacteria), with a significance threshold of α = 0.05. The analysis revealed a highly significant difference (P = 0.0012, t-value = 28.34), confirming that the observed weight reduction was attributable to microbial activity rather than abiotic factors. One-way ANOVA further demonstrated substantial variance between groups, with an F-value of 14,444.44. Kinetic analysis using a first-order degradation model yielded a reduction rate constant (K) of 0.00758 day-1 and a corresponding half-life (t1/2) of 91.48 days, indicating a moderate yet promising degradation capability of Bacillus cereus under laboratory conditions. These results are summarized in Tables 3 and 4 and visually represented in Figure 5, which shows the dry weight loss of PS MPs following Bacillus cereus treatment.
Figure 5. Comparison of dry weight loss of PS between control and Bacillus cereus (BI) treatment, indicating biodegradation efficiency. PS: Polystyrene.
Biodegradation efficiency of Bacillus cereus (BI) compared to control based on PS dry weight loss and growth parameters
| Sample | OD at 600 nm | pH | Temp (°C) | Initial (gms) | Final (gms) | Reduction (gms) | Dry weight loss (%) |
| Control (PS) | 0.02 | 7.16 | 26.8 | 0.03 | 0.0298 | 0.0002 | 0.67 |
| BI (PS) | 0.8 | 7.16 | 26.8 | 0.03 | 0.0239 | 0.0061 | 20.33 |
Statistical significance and biodegradation kinetics of PS degradation by Bacillus cereus
| P-value (vs. control) | 0.0012 |
| t-value | 28.34 |
| F-value (variance ratio) | 14,444.44 |
| Reduction rate constant (K) | 0.00758 day-1 |
| Half-life (t1/2) | 91.48 days |
Biofilm formation and surface interaction
Biofilm formation on PS surfaces plays a critical role in enhancing microbial degradation by providing structural support, facilitating enzyme production, and increasing substrate accessibility[14,16]. In the present study, SEM revealed significant biofilm formation on PS surfaces. This was indicated by the adherence of bacterial cells to the PS surface, suggesting strong bacterial attachment and colonization. Biofilm formation is a key factor that promotes the degradation of recalcitrant polymers such as PS, as it enhances localized enzyme production and increases contact between microbial cells and the substrate. These findings are consistent with previous reports of substantial biofilm formation by Pseudomonas aeruginosa on plastic surfaces during degradation experiments[20]. Biofilm development is influenced by multiple factors, including nutrient availability, surface properties of the plastic, and environmental conditions such as temperature and pH. The optimal conditions recorded in this study (pH 7.16 and temperature 26.8 °C) likely contributed to efficient biofilm formation and subsequent biodegradation.
FTIR analysis
FTIR spectroscopy was employed to assess structural and chemical changes in PS MPs before and after exposure to Bacillus cereus. Comparative spectra of pristine, control, and test samples were analyzed to identify key indicators of microbial degradation. The FTIR spectrum of pristine PS [Figure 6A] exhibited characteristic peaks of a stable aromatic polymer structure, including aliphatic C–H stretching vibrations at 2,850-2,950 cm-1, aromatic C–H stretching around 3,025 cm-1, aromatic C=C skeletal vibrations at 1,600 and 1,450 cm-1, and C–H bending at 756 and 698 cm-1, indicative of mono-substituted benzene rings. These features represent the standard fingerprint of intact PS, showing no signs of oxidative or structural alteration. The control PS spectrum (incubated without bacterial inoculum; Figure 6B) closely resembled that of pristine PS, with characteristic aromatic and aliphatic peaks largely unchanged. However, weak absorption bands corresponding to carbonyl stretching (~1,700 cm-1) and a broad O–H band (~3,300-
Figure 6. FTIR Spectra of PS MPs. (A) Pristine PS - Typical peaks of intact PS: aliphatic C–H (2,850-2,950 cm-1), aromatic C–H
SEM analysis
Qualitative determination of biofilm production
SEM was used to qualitatively evaluate morphological alterations on PS surfaces following bacterial exposure, with emphasis on biofilm formation. The control PS [Figure 7A] exhibited a smooth and intact surface, confirming the absence of microbial colonization or degradation. In contrast, the test sample
Figure 7. SEM images of PS MP surfaces after 30 days under different conditions. (A) Control PS surface showing smooth, unaltered morphology in the absence of bacterial treatment; (B) PS surface inoculated with bacteria, exhibiting dense biofilm formation with EPS aggregates indicating active microbial colonization. A magnified image at 5 μm is also shown; (C) PS surface after biofilm removal, displaying visible surface degradation such as cracks, pits, and erosion, signifying post-biofilm structural alterations caused by bacterial activity. SEM: Scanning electron microscopy; PS: polystyrene; MP: microplastic; EPS: extracellular polymeric substance.
After biofilm removal [Figure 7C], the PS surface still displayed pronounced degradation features, such as micro-cavities, cracks, and increased surface roughness. These residual marks confirm irreversible microbial degradation, likely mediated by oxidative and hydrolytic enzymes such as monooxygenases and laccases. The biofilm microenvironment further supported quorum sensing and nutrient exchange, promoting polymer chain cleavage. The structural changes observed via SEM corroborated the FTIR results, which revealed the formation of oxidative functional groups, suggesting a progressive degradation mechanism involving adhesion, enzymatic attack, and polymer backbone disruption. These findings align with previous reports on Pseudomonas and Rhodococcus species, and further highlight Bacillus cereus as a promising biofilm-forming bacterium for PS MP degradation through enzymatic activity and surface colonization.
Quantitative determination of biofilm production (CV assay)
Biofilm formation on PS surfaces was quantitatively assessed using CV staining followed by spectrophotometric measurement at OD595. As shown in Figure 8, the OD595 value for the Mula PS sample (0.090 ± 0.005) was significantly higher than that of the sterile control PS (0.010 ± 0.002) and the control PS treated with CV alone (0.012 ± 0.002). These results quantitatively confirm substantial microbial colonization and biofilm development on PS surfaces, consistent with the morphological evidence from SEM observations. Together, the SEM imaging and CV assay clearly demonstrate that biofilm formation enhances microbial attachment and enzymatic degradation of PS MPs.
Previous studies have identified Bacillus cereus as a promising plastic-degrading microorganism. This species can degrade both polyethylene and PS, as supported by morphological and structural changes observed through SEM and FTIR analysis[31]. LDPE degradation by Bacillus cereus, evidenced by measurable weight loss and microbial colonization under laboratory conditions, has also been reported[32]. In line with these findings, the present study showed that Bacillus cereus isolated from the Mula River effectively degraded PS MPs, as indicated by significant dry weight loss, biofilm formation, and FTIR spectral changes. These results reinforce the potential of Bacillus cereus as a bioremediation agent for plastic waste, particularly in freshwater environments impacted by anthropogenic pollution.
Recent studies have highlighted several bacterial strains capable of plastic degradation, with efficiencies varying according to substrate type and environmental conditions. Ideonella sakaiensis efficiently degrades PET via the enzymes PETase and MHETase but does not act on PS[33,34]. Pseudomonas putida exhibits moderate PS degradation, achieving approximately 10%-15% weight loss over 30 days under enriched media and shaking conditions[35]. Similarly, Rhodococcus ruber and Microbacterium esteraromaticum can induce surface oxidation and partial PS weight loss, often requiring longer incubation periods and biofilm adaptation[36,37]. In comparison, the current study demonstrates that Bacillus cereus achieved 20.33% PS weight loss within just 30 days, along with visible surface erosion under SEM and oxidative functional group transformations observed via FTIR. These results suggest that Bacillus cereus performs comparably or even more efficiently than several previously reported strains, making it a promising candidate for PS biodegradation, especially considering its robust biofilm formation and adaptability under mild environmental conditions.
Our findings demonstrate the moderate but promising capability of Bacillus cereus to degrade PS MPs under laboratory conditions. While microbial degradation of PS offers a sustainable approach to plastic waste mitigation, the environmental implications of intermediate by-products remain a critical concern. Incomplete degradation may generate smaller PS fragments or toxic monomers, such as styrene, which are known to exert neurotoxic, endocrine-disrupting, and cytotoxic effects[38]. These by-products may accumulate in aquatic organisms, inducing oxidative stress, inflammatory responses, and disruption of metabolic pathways. Fragmented MPs may also enhance the adsorption and transport of persistent organic pollutants and heavy metals, increasing ecological risk[39]. Hence, it is essential to complement biodegradation studies with toxicological and chemical profiling of end-products to ensure that microbial degradation leads to environmentally safe outcomes.
CONCLUSION
The present study successfully identified a Gram-positive, rod-shaped, motile bacterium, Bacillus cereus, capable of degrading PS MPs under laboratory conditions. Molecular identification through 16S rRNA gene sequencing and BLAST analysis revealed 100% sequence similarity with multiple Bacillus cereus strains, confirming its taxonomic classification. To accurately assess degradation, PS MPs were carefully recovered and processed after incubation. Visible MP particles were retrieved using sterile forceps, followed by SDS treatment and thorough rinsing to remove residual biofilm. This step was essential to ensure that measured weight loss reflected true microbial degradation rather than biomass attachment. Biochemical assays confirmed the metabolic versatility and environmental resilience of the isolate, while growth in MSM with PS as the sole carbon source resulted in a 20% reduction in PS weight over 30 days. The calculated degradation rate constant (K = 0.00758 day-1) and half-life (t1/2 = 91.48 days) indicate a moderate but promising degradation potential. Spectroscopic and microscopic analyses further validated the biodegradation process. FTIR spectra revealed the emergence of hydroxyl and carbonyl functional groups, indicating polymer oxidation and chain scission. SEM imaging showed extensive biofilm formation and surface deterioration of PS, including pits and cracks, confirming enzymatic action and microbial colonization as key mechanisms in degradation. This workflow aligns with current best practices for detecting PS transformations, supporting reproducible assessment of Bacillus cereus-mediated PS degradation[40]. Overall, these findings underscore the bioremediation potential of Bacillus cereus in addressing PS MP pollution, particularly in freshwater environments. Future research should focus on elucidating the genetic and enzymatic pathways involved, identifying intermediate degradation products, and evaluating the feasibility of scaling the process for in situ environmental applications.
DECLARATIONS
Acknowledgements
The authors gratefully acknowledge Apex Biosciences for providing laboratory facilities and infrastructure essential for the successful completion of the experimental work.
Authors’ contributions
Made substantial contributions to the research design, data acquisition, analysis, interpretation and writing of the manuscript: Kumari, S.
Planned and supervised the research work and edited the manuscript: Nagpal, S.
Provided supervision and infrastructural support for the experimentation: Khan, S. A.
Provided assistance in editing and critically reviewed the manuscript: Chinglenthoiba, C.
Availability of data and materials
Data that support the findings are available from the corresponding authors upon reasonable request.
Financial support and sponsorship
None.
Conflicts of interest
All authors declared that there are no conflicts of interest.
Ethical approval and consent to participate
Not applicable.
Consent for publication
Not applicable.
Copyright
© The Author(s) 2025.
REFERENCES
1. Mohanan, N.; Montazer, Z.; Sharma, P. K.; Levin, D. B. Microbial and enzymatic degradation of synthetic plastics. Front. Microbiol. 2020, 11, 580709.
2. Nowak, B.; Pająk, J.; Drozd-bratkowicz, M.; Rymarz, G. Microorganisms participating in the biodegradation of modified polyethylene films in different soils under laboratory conditions. Int. Biodeterior. Biodegrad. 2011, 65, 757-67.
3. PlasticsEurope. Plastics - the fast Facts 2024. https://plasticseurope.org/knowledge-hub/plastics-the-fast-facts-2024/. (accessed 12 Sep 2025).
4. Lebreton, L.; Egger, M.; Slat, B. A global mass budget for positively buoyant macroplastic debris in the ocean. Sci. Rep. 2019, 9, 12922.
7. Cole, M.; Lindeque, P.; Halsband, C.; Galloway, T. S. Microplastics as contaminants in the marine environment: a review. Mar. Pollut. Bull. 2011, 62, 2588-97.
8. Wright, S. L.; Kelly, F. J. Plastic and human health: a micro issue? Environ. Sci. Technol. 2017, 51, 6634-47.
9. Wu, P.; Huang, J.; Zheng, Y.; et al. Environmental occurrences, fate, and impacts of microplastics. Ecotoxicol. Environ. Saf. 2019, 184, 109612.
10. Webb, H.; Arnott, J.; Crawford, R.; Ivanova, E. Plastic degradation and its environmental implications with special reference to poly(ethylene terephthalate). Polymers 2013, 5, 1-18.
11. Restrepo-Flórez, J.; Bassi, A.; Thompson, M. R. Microbial degradation and deterioration of polyethylene - a review. Int. Biodeterior. Biodegrad. 2014, 88, 83-90.
12. Danso, D.; Chow, J.; Streit, W. R. Plastics: environmental and biotechnological perspectives on microbial degradation. Appl. Environ. Microbiol. 2019, 85, e01095-19.
13. Yuan, J.; Ma, J.; Sun, Y.; Zhou, T.; Zhao, Y.; Yu, F. Microbial degradation and other environmental aspects of microplastics/plastics. Sci. Total. Environ. 2020, 715, 136968.
14. Lucas, N.; Bienaime, C.; Belloy, C.; Queneudec, M.; Silvestre, F.; Nava-Saucedo, J. E. Polymer biodegradation: mechanisms and estimation techniques. Chemosphere 2008, 73, 429-42.
15. Shah, A. A.; Hasan, F.; Hameed, A.; Ahmed, S. Biological degradation of plastics: a comprehensive review. Biotechnol. Adv. 2008, 26, 246-5.
16. Rummel, C. D.; Jahnke, A.; Gorokhova, E.; Kühnel, D.; Schmitt-Jansen, M. Impacts of biofilm formation on the fate and potential effects of microplastic in the aquatic environment. Environ. Sci. Technol. Lett. 2017, 4, 258-67.
17. Tania, M.; Anand, V. The implementation of microbes in plastic biodegradation. J. Umm. Al. Qura. Univ. Appll. Sci. 2025, 11, 208-18.
18. Wang, W.; Yao, S.; Zhao, Z.; et al. Degradation and potential metabolism pathway of polystyrene by bacteria from landfill site. Environ. Pollut. 2024, 343, 123202.
19. Sun, Y.; Zhang, Y.; Hao, X.; Zhang, X.; Ma, Y.; Niu, Z. A novel marine bacterium Exiguobacterium marinum a-1 isolated from in situ plastisphere for degradation of additive-free polypropylene. Environ. Pollut. 2023, 336, 122390.
20. Auta, H. S.; Emenike, C. U.; Fauziah, S. H. Distribution and importance of microplastics in the marine environment: a review of the sources, fate, effects, and potential solutions. Environ. Int. 2017, 102, 165-76.
21. Zhang, Y.; Pedersen, J. N.; Eser, B. E.; Guo, Z. Biodegradation of polyethylene and polystyrene: from microbial deterioration to enzyme discovery. Biotechnol. Adv. 2022, 60, 107991.
22. Pathak, V. M.; Navneet,
23. Gajendiran, A.; Krishnamoorthy, S.; Abraham, J. Microbial degradation of low-density polyethylene (LDPE) by Aspergillus clavatus strain JASK1 isolated from landfill soil. 3. Biotech. 2016, 6, 52.
24. Coughlin, S. A.; Mcfall, A.; Kelly, S. A.; Megaw, J. Polyolefin colonization and partial degradation by Gordonia sp., and Arthrobacter sp. isolated from wetlands and compost. Polym. Degrad. Stab. 2025, 241, 111558.
25. Emenike, C. U.; Jayanthi, B.; Agamuthu, P.; Fauziah, S. H. Biotransformation and removal of heavy metals: a review of phytoremediation and microbial remediation assessment on contaminated soil. Environ. Rev. 2018, 26, 156-68.
26. Lobelle, D.; Cunliffe, M. Early microbial biofilm formation on marine plastic debris. Mar. Pollut. Bull. 2011, 62, 197-200.
27. Tu, C.; Liu, Y.; Li, L.; et al. Structural and functional characteristics of microplastic associated biofilms in response to temporal dynamics and polymer types. Bull. Environ. Contam. Toxicol. 2021, 107, 633-9.
28. Sekhar, V. C.; Nampoothiri, K. M.; Mohan, A. J.; Nair, N. R.; Bhaskar, T.; Pandey, A. Microbial degradation of high impact polystyrene (HIPS), an e-plastic with decabromodiphenyl oxide and antimony trioxide. J. Hazard. Mater. 2016, 318, 347-54.
29. Jambeck, J. R.; Geyer, R.; Wilcox, C.; et al. Marine pollution. Plastic waste inputs from land into the ocean. Science 2015, 347, 768-71.
30. Raddadi, N.; Fava, F. Biodegradation of oil-based plastics in the environment: existing knowledge and needs of research and innovation. Sci. Total. Environ. 2019, 679, 148-58.
31. Hossain, S.; Shukri, Z. N. A.; Waiho, K.; et al. Biodegradation of polyethylene (PE), polypropylene (PP), and polystyrene (PS) microplastics by floc-forming bacteria, Bacillus cereus strain SHBF2, isolated from a commercial aquafarm. Environ. Sci. Pollut. Res. Int. 2024, 31, 32225-45.
32. Jebashalomi, V.; Emmanuel Charles, P.; Rajaram, R. Microbial degradation of low-density polyethylene (LDPE) and polystyrene using Bacillus cereus (OR268710) isolated from plastic-polluted tropical coastal environment. Sci. Total. Environ. 2024, 924, 171580.
33. Tournier, V.; Topham, C. M.; Gilles, A.; et al. An engineered PET depolymerase to break down and recycle plastic bottles. Nature 2020, 580, 216-9.
34. Yoshida, S.; Hiraga, K.; Takehana, T.; et al. A bacterium that degrades and assimilates poly(ethylene terephthalate). Science 2016, 351, 1196-9.
35. Miloloža, M.; Ukić, Š.; Cvetnić, M.; Bolanča, T.; Kučić, Grgić. D. Optimization of polystyrene biodegradation by Bacillus cereus and Pseudomonas alcaligenes using full factorial design. Polymers 2022, 14, 4299.
36. Eom, J.; Sarwar, A.; Lee, E. C.; et al. Cytotoxic effect and mechanism of nano-sized polystyrene degraded by Rhodococcus ruber C208. Chem. Eng. J. 2023, 473, 145094.
37. Davletgildeeva, A. T.; Kuznetsov, N. A. Bioremediation of polycyclic aromatic hydrocarbons by means of bacteria and bacterial enzymes. Microorganisms 2024, 12, 1814.
38. Li, J.; Zhang, K.; Zhang, H. Adsorption of antibiotics on microplastics. Environ. Pollut. 2018, 237, 460-7.
39. Menéndez-Pedriza, A.; Jaumot, J. Interaction of environmental pollutants with microplastics: a critical review of sorption factors, bioaccumulation and ecotoxicological effects. Toxics 2020, 8, 40.
Cite This Article
How to Cite
Download Citation
Export Citation File:
Type of Import
Tips on Downloading Citation
Citation Manager File Format
Type of Import
Direct Import: When the Direct Import option is selected (the default state), a dialogue box will give you the option to Save or Open the downloaded citation data. Choosing Open will either launch your citation manager or give you a choice of applications with which to use the metadata. The Save option saves the file locally for later use.
Indirect Import: When the Indirect Import option is selected, the metadata is displayed and may be copied and pasted as needed.
About This Article
Copyright
Data & Comments
Data

Comments
Comments must be written in English. Spam, offensive content, impersonation, and private information will not be permitted. If any comment is reported and identified as inappropriate content by OAE staff, the comment will be removed without notice. If you have any queries or need any help, please contact us at support@oaepublish.com.